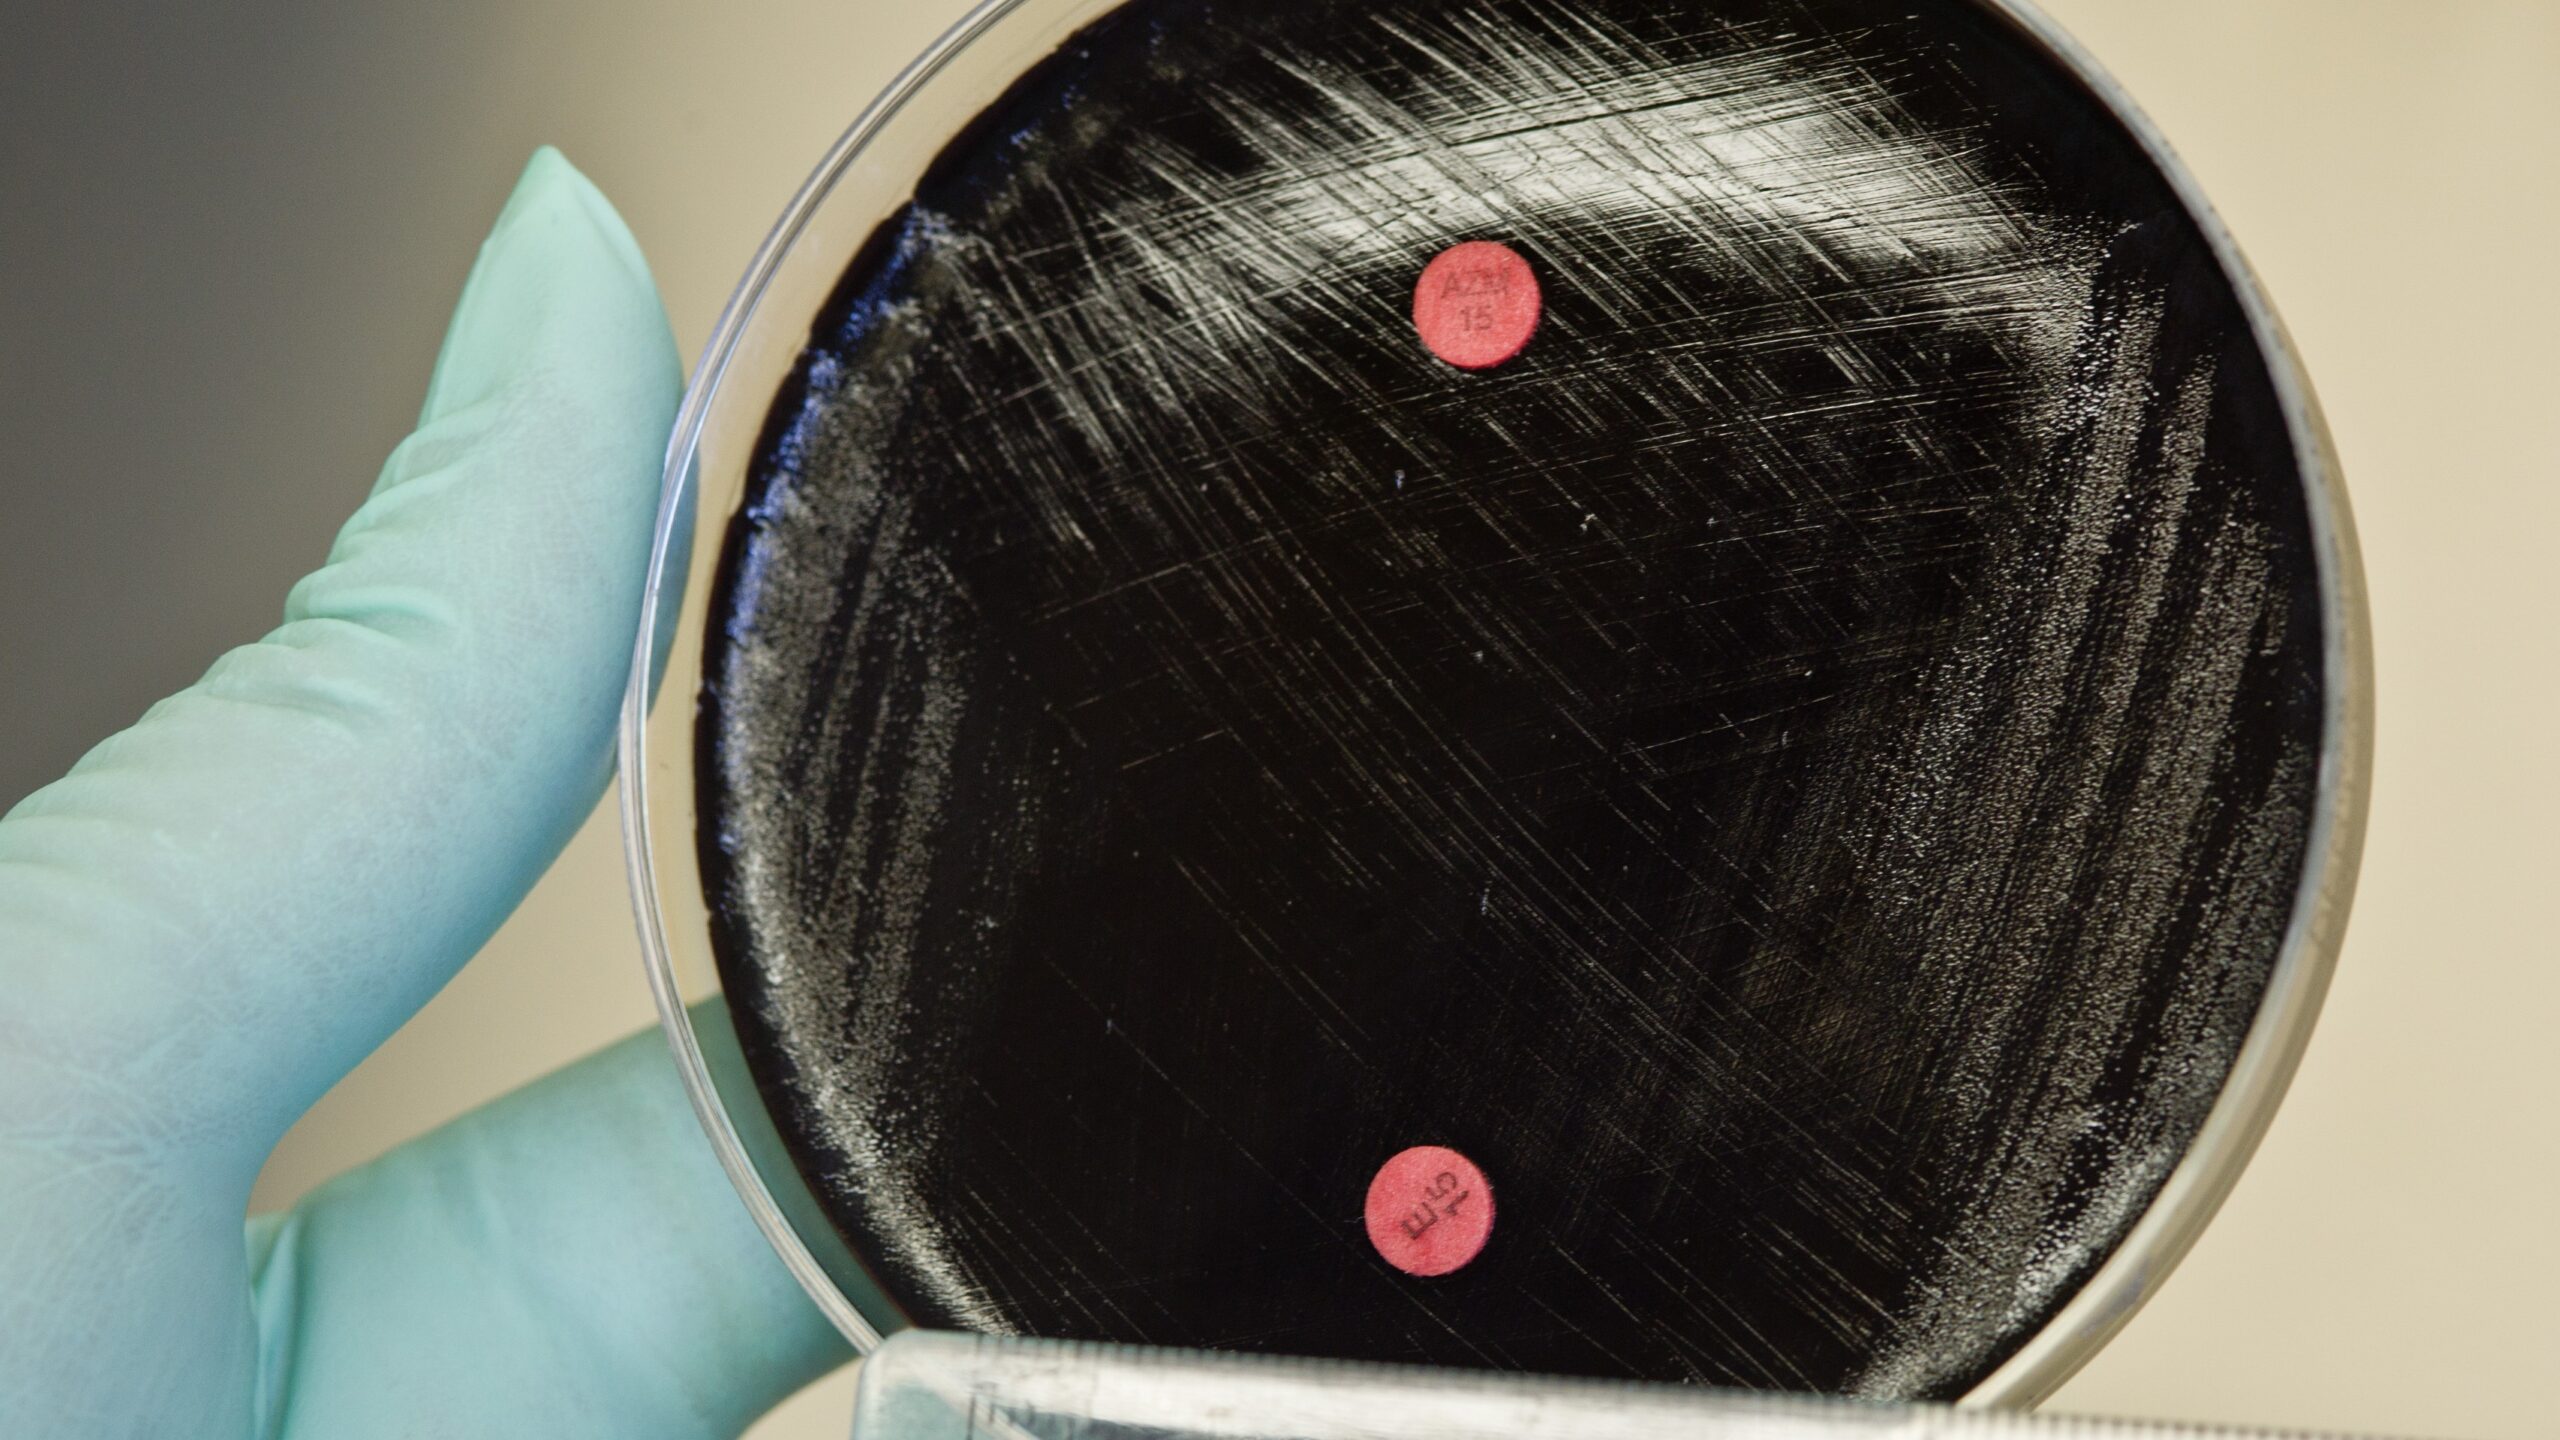
Macrolide-resistant Bordetella pertussis

Key points
- Macrolide-resistant Bordetella pertussis (MRBP) has been reported globally.
- In the United States, reported MRBP infections remain rare.
- There are several antibiotic resistance testing and antibiotic treatment options. Learn more below.
Resistance trends overview
Pertussis is an endemic respiratory disease that can be treated with macrolide antibiotics (e.g., azithromycin, clarithromycin, and erythromycin) or trimethoprim-sulfamethoxasole. In the past decade, resistance to macrolide antibiotics has been increasingly reported in other regions globally including Asia, Australia, Europe, and South America.
In the United States, reported resistance to macrolide antibiotics has been and remains rare.
Continued B. pertussis surveillance is needed to monitor for imported cases and changes in domestic strains. Learn more about CDC's surveillance activities and broader trends in pertussis.
Healthcare providers
Testing practices
With increases in MRBP globally, healthcare providers may consider antimicrobial resistance testing when diagnosing pertussis.
For patients with suspected pertussis who have recently traveled to countries with reported MRBP:
- Collect a nasopharyngeal specimen, if possible.
- Submit the specimen to your local or state public health department laboratory for culture and further testing. This testing would be done in addition to usual diagnostic testing.
Antibiotic selection
Treatment
If antibiotic resistance is detected, or if the patient is not demonstrating expected clinical improvement, providers may modify antibiotic choice. Trimethoprim-sulfamethoxazole can be used as an alternative to a macrolide antibiotic in patients aged ≥2 months who are infected with MRBP.
Post-exposure prophylaxis
If the index patient is known to have been infected with MRBP, trimethoprim-sulfamethoxazole is preferred, if not otherwise contraindicated.
Health department laboratories
Collecting and sending isolates
In the setting of increasing MRBP, further isolate characterization is important.
CDC encourages health department laboratories to:
- Culture specimens and perform B. pertussis testing and antibiotic resistance testing, if available
- Send B. pertussis isolates to CDC's Pertussis and Diphtheria Laboratory in Atlanta, GA for further testing and characterization
Testing methods
Macrolide resistance in B. pertussis can be detected phenotypically or predicted genotypically:
- Phenotypic
- Disk diffusion: Culture-based, screening method with antibiotic-infused disks
- Epsilometer test (Etest): Culture-based, quantitative screening method with antibiotic-infused strips
- Genotypic
- PCR: Molecular method that detects the genetic mutation (A2047G in the 23S rRNA gene) responsible for macrolide resistance in B. pertussis
- Whole-genome sequencing: Molecular method that detects the A2047G mutation and provides additional information characterizing the bacterial strain causing the infection
Currently no Clinical and Laboratory Standards Institute or European Committee on Antimicrobial Susceptibility Testing test methods or breakpoints have been established for B. pertussis. This includes methods such as broth microdilution or the use of Etest strips to determine a minimum inhibitory concentration.
